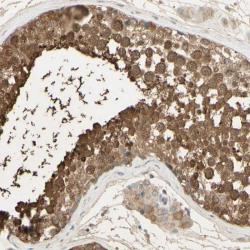

Antibody data
- Antibody Data
- Antigen structure
- References [4]
- Comments [0]
- Validations
- Western blot [1]
- Immunohistochemistry [1]
Submit
Validation data
Reference
Comment
Report error
- Product number
- sc-9087 - Provider product page

- Provider
- Santa Cruz Biotechnology
- Proper citation
- Santa Cruz Biotechnology Cat#sc-9087, RRID:AB_2155326
- Product name
- Anti-NR2C1
- Antibody type
- Polyclonal
- Antigen
- Recombinant full-length protein
- Reactivity
- Human
- Host
- Rabbit
Submitted references HDAC3 as a molecular chaperone for shuttling phosphorylated TR2 to PML: a novel deacetylase activity-independent function of HDAC3.
Retinoic acid-stimulated sequential phosphorylation, PML recruitment, and SUMOylation of nuclear receptor TR2 to suppress Oct4 expression.
SUMOylation of Tr2 orphan receptor involves Pml and fine-tunes Oct4 expression in stem cells
An embryonic/fetal beta-type globin gene repressor contains a nuclear receptor TR2/TR4 heterodimer.
Gupta P, Ho PC, Ha SG, Lin YW, Wei LN
PloS one 2009;4(2):e4363
PloS one 2009;4(2):e4363
Retinoic acid-stimulated sequential phosphorylation, PML recruitment, and SUMOylation of nuclear receptor TR2 to suppress Oct4 expression.
Gupta P, Ho PC, Huq MM, Ha SG, Park SW, Khan AA, Tsai NP, Wei LN
Proceedings of the National Academy of Sciences of the United States of America 2008 Aug 12;105(32):11424-9
Proceedings of the National Academy of Sciences of the United States of America 2008 Aug 12;105(32):11424-9
SUMOylation of Tr2 orphan receptor involves Pml and fine-tunes Oct4 expression in stem cells
Sung Wook Park, Xinli Hu, Pawan Gupta, Ya-Ping Lin, Sung Gil Ha, Li-Na Wei
Nature Structural & Molecular Biology 2006 Dec;14(1):68-75
Nature Structural & Molecular Biology 2006 Dec;14(1):68-75
An embryonic/fetal beta-type globin gene repressor contains a nuclear receptor TR2/TR4 heterodimer.
Tanabe O, Katsuoka F, Campbell AD, Song W, Yamamoto M, Tanimoto K, Engel JD
The EMBO journal 2002 Jul 1;21(13):3434-42
The EMBO journal 2002 Jul 1;21(13):3434-42
No comments: Submit comment
Supportive validation
- Submitted by
- per
- Main image

- Experimental details
- Western blot analysis of antibody specificity using a routine panel composed of IgG/HSA-depleted human plasma and protein lysates from selected human tissues and cell lines.
- Validation comment
- Band of predicted size in kDa (+/-20%) with additional bands present.
- Primary Ab dilution
- 1:500
- Secondary Ab dilution
- 1:3000
- Lane 1
- Marker [kDa]: 219, 111, 83, 48, 32, 26, 17
- Lane 2
- RT-4
- Lane 3
- U-251MG sp
- Lane 4
- Human Plasma
- Lane 5
- Liver
- Lane 6
- Tonsil
- Theoretical target weight
- [kDa] 67
Supportive validation
- Submitted by
- per
- Main image
- Experimental details
- Immunohistochemical staining of human testis shows distinct cytoplasmic positivity in cells of seminiferus ducts.
- Validation comment
- No experimental and/or bioinformatic data available, or staining pattern not consistent with experimental and/or bioinformatic data.